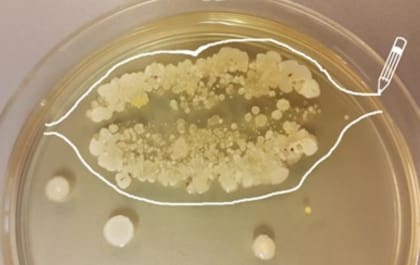
Cada beso contiene millones de microorganismos

Cuántas bacterias hay en un beso
La UADE realizó un experimento a propósito de la semana de la dulzura
1 minuto de lectura'
A propósito de la semana de la dulzura, la Facultad de Ingeniería y Ciencias Exactas de Fundación UADE realizó una prueba en UADE Labs para mostrar las bacterias que se esconden detrás de un beso.
La prueba se realizó con una placa de Petri, un recipiente que contiene sustancias que hacen que las bacterias crezcan al punto de hacerse visibles al ojo humano, informó UADE en un comunicado.
Los resultados del experimento se pueden ver en la foto de arriba. "Si tuviéramos la capacidad de observar a nuestro alrededor con un aumento de unas 100.000 veces, podríamos ver todo el tiempo miles de millones de organismos vivos que se mueven, respiran y se pasean a nuestro lado, ingresando a nuestro cuerpo por la boca, la nariz, los oídos, los ojos, las heridas, etc. La boca, especialmente, es uno de los principales lugares por donde ingresan estos "bichitos", ya sea a través de los alimentos, del propio aire, y también cuando besamos", indica el comunicado de UADE.
¿Cuántas bacterias hay?
A su vez, el texto cita estudios internacionales, como el realizado por la Organización de Investigación Científica Aplicada (TNO) de Holanda y publicado en la revista Microbiome, que indican cuántas bacterias hay en un beso.
Según la investigación, durante un beso en la boca se intercambian más de 80 millones de bacterias, distribuidas en 700 tipos. "El ser humano promedio tiene más de 100 millones de bacterias por centímetro cúbico de saliva. A partir de este trabajo, realizado a partir de muestras de saliva de 21 voluntarios, se demostró que estas bacterias nos preservan de ciertas enfermedades", dice el comunicado.
"En definitiva, hay que continuar besándose sin temores a pesar de los millones de bacterias que nos transmitimos con cada beso porque eso, al fin y al cabo, nos mantiene con las defensas altas", concluye UADE.
¿Por qué les gusta tanto la boca a los microorganismos?
La boca genera condiciones favorables para que los microorganismos vivan y se multipliquen: tienen alimentos frescos, buena temperatura, y humedad.
En algunos casos los microorganismos ayudan con al metabolismo. Muchos de ellos son indispensables para nuestra vida. Pero también "puede aparecer alguno no tan deseado, que si nuestro sistema inmune no lo bloquea correctamente puede llegar a ocasionarnos alguna enfermedad", dice UADE.
Cómo minimizar las posibilidades de ingerir organismos patógenos
- Cocinar bien los alimentos.
- En caso de que no requieran cocción, como las ensaladas vegetales, lavar todo muy bien. Incluso utilizar una gotita de lavandina y dejar unos minutos en remojo.
- Lavarse bien las manos antes de manipular alimentos.
- No utilizar el mismo utensilio para manipular los alimentos crudos y los cocidos.



